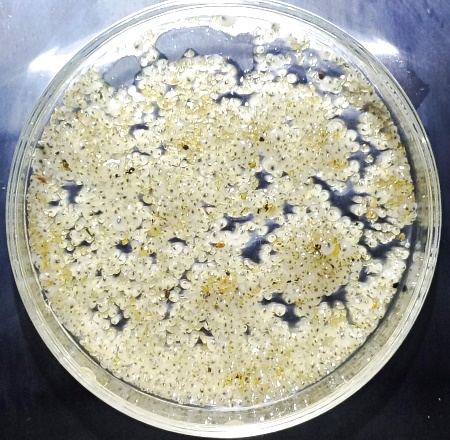

花都影视 滩涂贝类良种培育与增养殖创新团队师生落实“重实践,建新功”要求,在暑假期间深入海岛渔村,与辽宁安德食品有限公司、山东明波水产有限公司、大连上品堂海洋生物有限公司、獐子岛集团股份有限公司、山东正海集团有限公司联合开展蛤仔等滩涂贝类良种培育、苗种繁育与健康养殖技术研发与科技成果转化工作及访企拓岗,助推黄渤海滩涂贝类增养殖产业健康可持续发展。
1、蛤仔良种开拓滩涂养殖新空间
团队与辽宁安德食品有限公司合作开展“斑马蛤2号”新品种规模化养殖,并邀请专家对庄河海域养殖的“斑马蛤2号” 进行现场验收。“斑马蛤2号”经过连续2年的养殖平均壳长达到41.00 mm,并在辽宁庄河水深<3 m的海域安全越冬,有望使水深<3 m浅海及荒芜滩涂,以及受汛期影响不能养殖蛤仔的海区得到恢复利用(图1)。




图1 辽宁庄河“斑马蛤2号”现场验收
2、本地化蛤仔苗种培育初显成效
团队与莱州明波水产有限公司合作,在山东招远、昌邑等地开展土著蛤仔良种选育(图2、3)、室内苗种规模化繁育及中间培育池塘水质调控技术研究,累计培育优质本地蛤仔苗种50亿粒,为蛤仔苗种稳产增收提供技术保障。





图2 蛤仔优质抗逆新品系选育与苗种规模化繁育


图3 山东昌邑蛤仔中间培育池塘水质智慧监测
团队与丹东东港市渔业渔民渔船管理局在丹东东港市双峰岛蛤仔中培池塘安装养水机调控池塘水质,降低了夏季池塘表底层出现温跃层及盐跃层给蛤仔苗种中间培育带来的潜在风险(图4)。


图4 蛤仔中培池塘养水机
3、滩涂贝类人工苗种家族再添新丁
团队与獐子岛集团股份有限公司在獐子岛原良种场联合开展紫石房蛤健康苗种培育关键技术研究。针对目前紫石房蛤人工苗种短缺的现状,开展环境因子对紫石房蛤幼虫与稚贝生长发育影响研究,建立了一套适合我国北方海域的紫石房蛤人工苗种繁育技术,成功培育1.5 mm以上紫石房蛤苗种200余万粒(图5)。
团队与大连上品堂海洋生物有限公司在庄河石城岛开展象拔蚌苗种繁育技术成果转化应用,并选育能够在我国北方海域安全度夏的壳长>1 mm的象拔蚌稚贝5万粒(图6)。

图5 紫石房蛤室内工厂化苗种培育


图6 象拔蚌室内工厂化苗种培育与度夏苗种
4、滩涂贝类养殖海区成为研究生实践锻炼新阵地
团队与山东正海集团在无棣县贝壳堤岛,开展海域水质调查(图7),为公司贝类养殖海域功能区划提供科学依据。



图7 滨州正海公司新确权海域水质调查
团队在丹东东港市辽宁安德食品有限公司蛤仔养殖海区环境及蛤仔生长情况进行跟踪监测(图8)。




图8 丹东东港蛤仔养殖海区环境及生长跟踪监测

